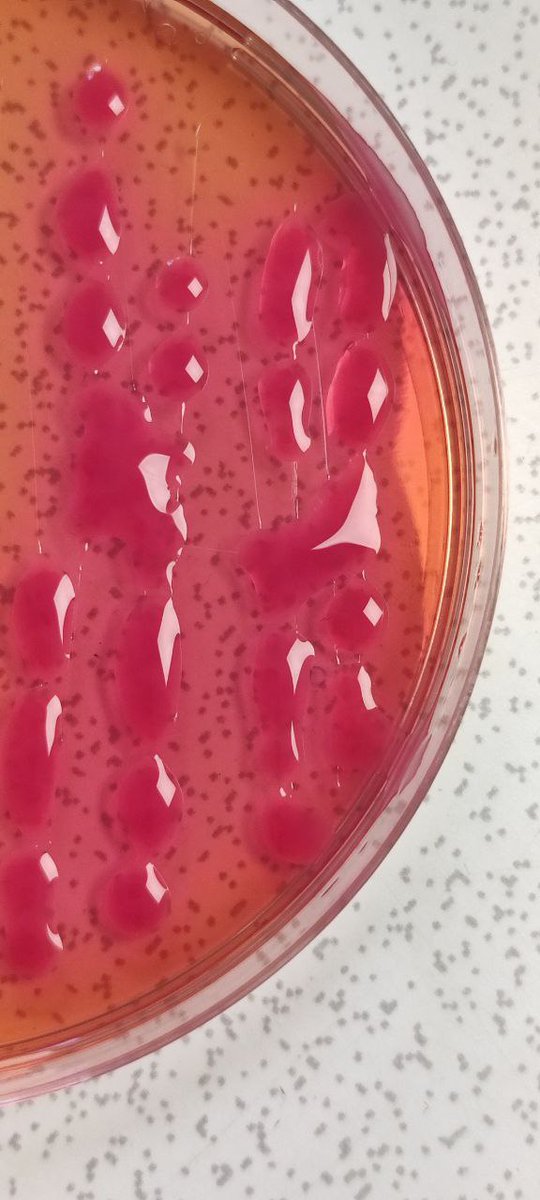
Klebsiella species? I know you are more likely to agree, especially if you don't have enough resources for identification.

This is Pantoea species.

Brethren,  if you don't know an organism ID, and the sensitivity test shows many resistance,  don't conclude the patient is

Fajobi Timothy
@king_olu_faj
Medical Laboratory Scientist | Inner Circle Trader📈💻 📉| Kingdom Ambassador
ID: 2213440401
https://www.linkedin.com/in/timothy-oluwatobi-fajobi-26b15816a?utm_source=share&utm_campaign=share_v 08-12-2013 06:20:54
2,2K Tweet
703 Takipçi
892 Takip Edilen